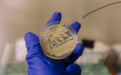
NASA洁净室惊现“装死细菌”：通过“代谢关闭”休眠，骗过灭菌检测

一种罕见微生物能够进入极度休眠状态,其本质就像是在“装死”,从而得以在地球上最洁净的环境中存活下来。
通过“代谢关闭”获得耐受力,处于休眠状态
美国休斯顿大学微生物学家发布的研究显示,一种名为“凤凰特氏球菌”的罕见细菌,通过进入休眠状态成功躲避了美国宇航局(NASA)航天器组装洁净室的检测。这一发现可能会重塑科学家对微生物生存能力的认知,并对太空任务中的防污染挑战提出新的课题。
▲在航天器洁净室发现的凤凰特氏球菌
这种名为“凤凰特氏球菌”的微生物最初是在十多年前被发现的。当时,为了防止微生物污染航天器及其他星球,在美国佛罗里达州和法属圭亚那的两个洁净室中,设施经过极其严格的清洁。有科学家却意外发现,在这种环境下,竟然还有微生物存在。即便环境有利于它们,这种细菌仍能保持非活性状态,使得标准的灭菌检测很难发现它们。
为了解开谜团,休斯顿大学生物学与生物化学系的研究助理教授马达汉·蒂鲁马莱与威廉·威杰教授、研究生萨哈尔·阿里等人展开合作研究。
研究团队发现,这种细菌不形成孢子(通常形成孢子被认为是细菌具备极度耐受性的特征),但它却能通过“代谢关闭”获得耐受力。蒂鲁马莱指出,这些细菌进入了一种代谢活动极低、停止生长的休眠状态。
“最让我感到意外的是,这些微生物并不形成孢子,”佛罗里达大学微生物学与细胞科学系助理教授阿弗雷施说,“看到一种不形成孢子的细菌仅靠关闭新陈代谢就能获得相当的耐受力,这表明细菌中还存在其他未被充分重视的生存机制,而我们需要对其进行全面解析。”
无菌环境面临挑战,研究有助于控制致病细菌
研究人员利用一种在放线菌中常见的“复苏促进因子”蛋白质进行测试。威杰教授描述了实验结果:“当我们加入这种蛋白质时,‘凤凰特氏球菌’的细胞‘醒了过来’。”这一实验证实,该细菌确实可以通过“装死”来度过营养匮乏期,并以此抵抗航天器洁净室中的严苛条件。
阿弗雷施在接受采访时表示:“这表明,某些微生物可以进入超低代谢状态,从而在极度严苛的环境中生存下来,其中就包括会对最顽强的生物进行自然筛选的洁净室环境。”
阿弗雷施强调:“这种细菌能够主动暂停其新陈代谢,这一事实使得微生物在航天器表面存活或在深空飞行期间幸存的可能性,比我们之前设想的要大得多。”防止污染不仅有助于保障太空任务的安全,还能确保人类在太阳系其他地方发现的任何生命迹象都是真实可信的,而非地球带来的“偷渡客”。
休斯顿大学的研究团队指出,除了航天器组装设施,休眠的放线菌可能还隐藏在医院、制药实验室和食品加工厂等其他无菌环境中。威杰警告称,其他行业可能忽略了这些细菌可以通过休眠来躲避检测这一概念:“我们不知道它们是否会变成有害细菌,但知道它们是否存在总是好的。”
此外,这一发现可能有助于控制致病细菌,例如导致结核病的细菌。如果科学家能找到防止这些细菌进入潜伏期的方法,或者在它们进入休眠前将其杀灭,抗生素或灭菌技术将变得更加有效。
红星新闻记者 邓纾怡 编辑 张寻 审核 冯玲玲
“特别声明:以上作品内容(包括在内的视频、图片或音频)为凤凰网旗下自媒体平台“大风号”用户上传并发布,本平台仅提供信息存储空间服务。
Notice: The content above (including the videos, pictures and audios if any) is uploaded and posted by the user of Dafeng Hao, which is a social media platform and merely provides information storage space services.”